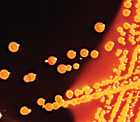
bacteria

Types of Healthcare-associated Infections
Modern healthcare employs many types of invasive devices and procedures to treat patients and to help them recover. Infections can be associated with the devices used in medical procedures, such as catheters or ventilators.
These healthcare-associated infections (HAIs) include central line-associated bloodstream infections, catheter-associated urinary tract infections, and ventilator-associated pneumonia. Infections may also occur at surgery sites, known as surgical site infections. CDC works to monitor and prevent these infections because they are an important threat to patient safety.
Diseases and Organisms
See the library of
Infection Control Guidelines
- Page last reviewed: March 26, 2014
- Page last updated: March 26, 2014
- Content source:


 ShareCompartir
ShareCompartir